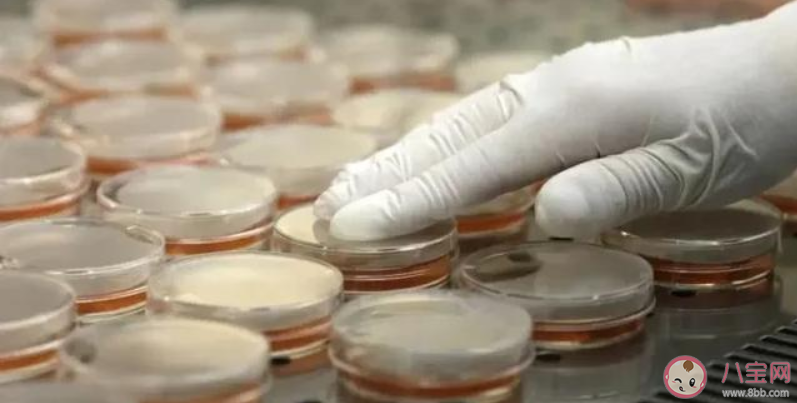
全身哪個地方最容易沾上新冠狀病毒 與感染者密切接觸沒感染是怎么回事

時間:2020-02-27 14:21:31來源:本站整理作者:xl點擊:
新冠狀病毒疫情雖然相比之前要好一些,但和密切接觸者還是要注意防控,人體全身,頭發的感染率較低,手沾上病毒的概率大,那么,全身哪個地方最容易沾上新冠狀病毒?與感染者密切接觸沒感染是怎么回事?下面八寶網小編就來說說。

頭發感染率低,只需日常清潔即可。
新冠病毒不能透過皮膚侵入人體,但是手“沾”病毒概率極大,眼膜感染率高,手部消毒前不要揉眼,要用正確方法勤洗手。
手機屬于高頻接觸物品,回家后需消毒。
衣服感染率較低,沒去過特定場所,不需要消毒。
鞋底感染率同樣較低,只要保持清潔,在門口換鞋即可。
1、感染者自我隔離的好
在接觸其他人的過程中,出現病毒傳播的可能性也是無法杜絕的,但同時也說明了,如果感染者能夠注意自我隔離,盡量避免與其他人接觸,也不一定會傳染給其他人員。
因此,對于出現疑似癥狀的情況下,就應該積極的自我隔離,盡量減少密切接觸的情況,已經有過密切接觸的其他人,也要密切觀察相關癥狀,做好自我防護和隔離。
2、接觸者防護做的好
家中有新冠病毒感染者的情況下,如果能夠積極的做好隔離,同時其他家人都有良好的防護習慣和衛生習慣,在未確診前,能夠在家戴好口罩,勤通風,施行分餐,不與疑似病患共餐,勤洗手,不用不潔凈的手觸摸口鼻,勤消毒,多注意,做到這些點,就能夠大大的減少病毒傳播的幾率,做好防護的感染者接觸者,比起不注意防護的接觸者,其感染風險當然就會大大降低。
3、不同個體病毒易感性不同
有的時候出現了確診患者,與其密切接觸的其他家人全軍覆沒,全都感染了新型冠狀病毒,而還有很多時候,感染者密切接觸的家人中,只有其他一人或兩人被傳染,而其他家庭成員則未被感染,相信這與個人的身體素質,對于新型冠狀病毒的易感性有一定的關系。
同樣是生活在一個屋檐下,有的人身體素質比較好,免疫力較強,沒有被病毒感染,而有的人則比較容易被感染,于是被輕易的就傳染了,到底何種情況屬于易感的情況,何種情況屬于不易感的情況,目前還沒有相應的明確研究,但相信隨著我們對這種新型病毒研究的不斷深入,這些問題的真相,也會逐漸浮出水面。
還有一種情況值得考慮,就是也可能有這樣的一種可能性,新型冠狀病毒實際上已經形成了感染,但感染者沒有出現任何癥狀,甚至核酸檢測也未檢測到,經過很短的時間,這種病毒的感染已經被清除,這種隱性感染者是否存在,也是值得我們考慮和研究的。

1、增強自身的抵抗力和免疫力。
這是抵抗病毒最關鍵的一條,因為只有強大的免疫力才能用自身的力量將病毒殺死,才能保住自己的健康。而對于一些年老體弱的人,如果日常飲食滿足不了提升免疫力的需要,建議可以服用一些品牌的蛋白質粉或者注射一些可以提升免疫力的生物制劑,來保證身體足夠的抗病能力。
2、進行體育鍛煉。
抵抗病毒提升抵抗力的另一個方法就是進行身體的鍛煉,因為鍛煉身體可以增強身體的體質,改善血液循環,提升各個器官的活力,因此,可以提升抵御疾病的能力,疫情過后,一定要堅持每天做一定的戶外運動,這段時間出不去,可以在家里做活動。
3、經常戴口罩。
這次疫情告訴我們,現在病毒的傳播方式主要是空氣飛沫傳播,這種傳播方式非常快,但是,戴上口罩就可以避免病毒通過口鼻進入我們的身體,這是給健康的第一道屏障,因此,以后出門的時候也可以戴口罩,如果自己出現咳嗽和發熱的癥狀,外出也最好戴上口罩。這段時間是絕對要戴口罩的,只要是走出家門口罩是必戴的。請大家一定要記住。
4、養成良好的生活習慣。
要堅持經常洗手,要經常開窗戶通風,保持室內的空氣新鮮,還有保證每天按時的睡覺,擁有充足的睡眠。
5、發熱及時就診。
如果出現干咳、發燒-全身不適等癥狀,千萬不要自己亂買藥吃,一定要去醫院進行診治,以確診是否具有傳染性,這樣可以避免流行性疾病的進一步傳播,是保護自己也是保護他人。
以上就是有關全身哪個地方最容易沾上新冠狀病毒,與感染者密切接觸沒感染是怎么回事介紹,想了解更多信息請繼續關注。
網友跟帖
Copyright 2015-2020 8bb.com 〖八寶網〗 版權所有 鄂ICP備19016373號-1
聲明: 本站文章均來自互聯網,不代表本站觀點 如有異議 請與本站聯系 本站為非贏利性網站 不接受任何贊助和廣告
網友評論僅供其表達個人看法,并不表明八寶網立場。